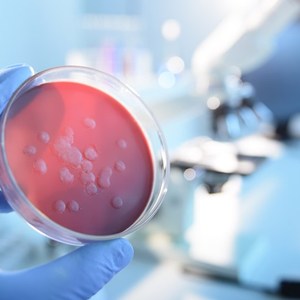
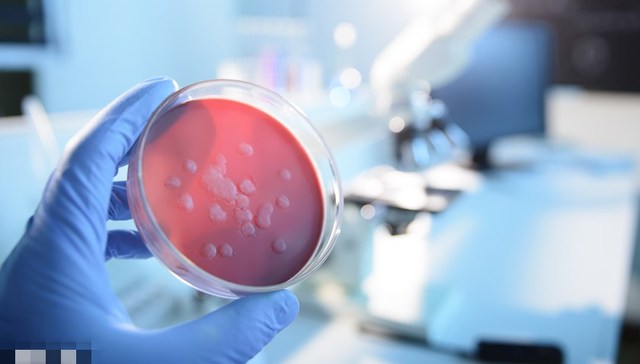
直通部委 | 4月全国报告法定传染病210万例 民政部将探索建立婚姻领域个人信用制度

疾控局:4月全国报告法定传染病210万例,死亡2217人
5月25日,国家疾控局发布2023年4月全国法定传染病疫情概况。2023年4月1日0时至4月30日24时,全国(不含香港、澳门特别行政区和台湾地区)共报告法定传染病2101158例,死亡2217人。甲类传染病无发病、死亡病例报告。乙类传染病中,传染性非典型肺炎、脊髓灰质炎、白喉、人感染高致病性禽流感和人感染H7N9禽流感无发病、死亡病例报告;除新型冠状病毒感染外,其余21种乙类传染病共报告发病291128例、死亡2185人。报告发病数居前5位的病种依次为病毒性肝炎、肺结核、梅毒、淋病及布鲁氏菌病,占乙类传染病报告病例总数的96%。同期,丙类传染病共报告发病1810030例,报告死亡32人。报告发病数居前3位的病种依次为流行性感冒、其他感染性腹泻病和手足口病,占丙类传染病报告病例总数的99.5%。
两高:胁迫、诱骗未成年人网络裸聊的以猥亵罪处罚
最高人民法院、最高人民检察院5月25日联合发布《最高人民法院、最高人民检察院关于办理强奸、猥亵未成年人刑事案件适用法律若干问题的解释》,从2023年6月1日起实施。《解释》坚持严字当头,进一步明确了相关犯罪的入罪条件和从重、加重处罚情节认定标准。例如,明确胁迫、诱骗未成年人网络裸聊的以猥亵罪处罚;明确列举对奸淫幼女、强奸未成年人适用较重的从重处罚幅度的多项情形;明确强奸、猥亵“情节恶劣”“造成被害人伤害”等多项加重处罚情形;明确对此类犯罪严格控制缓刑适用,以及依法适用禁止令、从业禁止。这对于进一步统一法律适用标准、加大惩处力度,具有重要指导意义。
两高两部:性侵害未成年人案件由专门机构或人员办理
5月25日,最高人民法院、最高人民检察院、公安部、司法部联合发布《最高人民法院、最高人民检察院、公安部、司法部关于办理性侵害未成年人刑事案件的意见》。《意见》强调有案必立,公安机关接到未成年人被性侵害的报案、控告、举报,符合刑事立案条件的,立即立案侦查,重大、疑难、复杂案件立案审查期限原则上不超过七日;对性侵害未成年人的成年犯罪嫌疑人、被告人,从严把握适用非羁押强制措施,严格把握减刑、假释等;持续推进强制报告、入职查询法律制度落实。《意见》明确性侵害未成年人案件办理基本原则。强调性侵害未成年人案件应当由专门机构或者专门人员办理。人民检察院依法对相关诉讼活动进行法律监督。

14部门联合发文:推进“双千兆”网络统筹集约建设
据“工信微报”微信公众号5月25日消息,近日,工信部等14部门联合印发了《关于进一步深化电信基础设施共建共享 促进“双千兆”网络高质量发展的实施意见》。其中提到,推进“双千兆”网络统筹集约建设。充分发挥规划引领作用,加强通信基础设施专项规划与国家战略规划、国土空间规划、控制性详细规划等有效衔接,强化5G基站站址及机房、室内分布系统的建设需求统筹,严格杆路、管道、机房、光缆、基站接入传输线路等设施的共建共享流程,支持5G接入网共建共享,推进5G异网漫游。深化“双千兆”网络共同进入。严格执行新建住宅区和住宅建筑、商务楼宇、公共建筑内的通信配套设施工程建设标准,推进重点场所5G基站站址、机房及室内分布系统等设施统一协调进场、统筹开展建设,保障千兆光网平等接入。
民政部:6月1日起21个省份试点婚姻登记“跨省通办”
5月25日,民政部举行新闻发布会介绍,自2023年6月1日起,北京、天津等21个省(区、市)实施内地居民结婚登记和离婚登记“跨省通办”试点。试点地区婚姻登记机关统一受理婚姻登记“跨省通办”事项,扩大试点后的21个省份将覆盖我国总人口的78.5%。自2021年6月1日起,民政部在辽宁、山东、广东、重庆、四川5省(市)部署开展了内地居民结婚和离婚登记“跨省通办”试点,在江苏、河南、湖北武汉、陕西西安2省2市开展了内地居民结婚登记“跨省通办”试点。截至2023年5月24日,试点地区累计“跨省”办理婚姻登记125247对。相关负责人表示,目前《婚姻登记条例》尚未完成修订,实现全国通办存在一定的法规障碍,待条件成熟后,将及时推动全国范围婚姻登记跨省通办工作。
民政部:探索婚姻领域个人信用制度,承诺不实纳入惩戒
5月25日,民政部举行新闻发布会,相关负责人表示,民政部门将积极采取措施,减少婚姻登记跨省通办后,重婚骗婚现象的发生。一是提升婚姻登记信息管理系统全国联网的稳定性和信息的完备性,强化婚姻登记全国联网审查功能,同时加强与相关部门的信息共享,及时对当事人身份信息和婚姻状况信息进行联网核验。二是要求各级婚姻登记机关配置智能化个人信息比对设备,提高婚姻当事人个人信息比对的准确性。三是探索建立婚姻领域个人信用制度,婚姻当事人签署个人婚姻状况承诺书,承诺不实将纳入个人信用惩戒范围。四是加强婚姻登记机关管理和工作人员培训,提升工作人员的政策水平和甄别能力。
教育部发布预警:坚决防范遏制学生溺水事件发生
据教育部5月25日网站消息,近期,全国各地气温迅速回升,汛期即将来临,溺水事故进入高发期,多地先后发生学生溺亡事件,令人痛心。教育部基础教育司特发布预防学生溺水工作预警,提醒各地教育行政部门和学校要高度重视,进一步强化预防学生溺水工作,切实保障学生生命安全。各地教育行政部门要提请属地党委政府,按照“属地管理、分级负责”和“谁主管、谁负责”的要求,明确教育、公安、民政、水利、农业农村等部门预防中小学生溺水工作职责分工。全面排查安全隐患,完善安全警示标识,配置安全防护设施,推动明确危险水域责任单位和责任人。此外,要加强宣传教育、密切家校联系。
教育部部署各地深入开展“2023高考护航行动”
据教育部网站5月25日消息,日前,教育部印发通知,部署各地教育部门和招生考试机构联合网信、公安等多个部门和多家互联网平台,深入开展“2023高考护航行动”。2023年高考期间,各地教育部门和招生考试机构将会同当地网信、公安等部门集中开展“高考护航”主题宣传、“清理互联网涉考公众账号”“点亮权威考试招生机构官网标识”等多个专项行动,积极营造良好考试环境,坚决维护教育考试公平。考后,各地将充分利用信息化手段,精心组织开展高考志愿填报专项咨询服务活动,多渠道、多方式为考生和家长提供政策解读、信息参考和咨询服务。
国家能源局:我国风电光伏发电总装机突破8亿千瓦
据国家能源局5月25日消息,截至今年4月底,我国风电装机3.8亿千瓦,光伏发电装机4.4亿千瓦,风电光伏发电总装机突破8亿千瓦,达到8.2亿千瓦,占全国发电装机的30.9%,其中风电占14.3%,光伏发电占16.6%。1-4月,全国风电光伏新增装机6251万千瓦,占全国新增装机的74%,同比增长11.5个百分点。其中,风电新增1420万千瓦、光伏发电新增4831万千瓦,分别占全国新增装机的16.8%和57.2%。1-4月,全国风电光伏发电量达到4828亿千瓦时,同比增长26.8%,占全社会用电量的17.2%,较去年同期增长3个百分点。